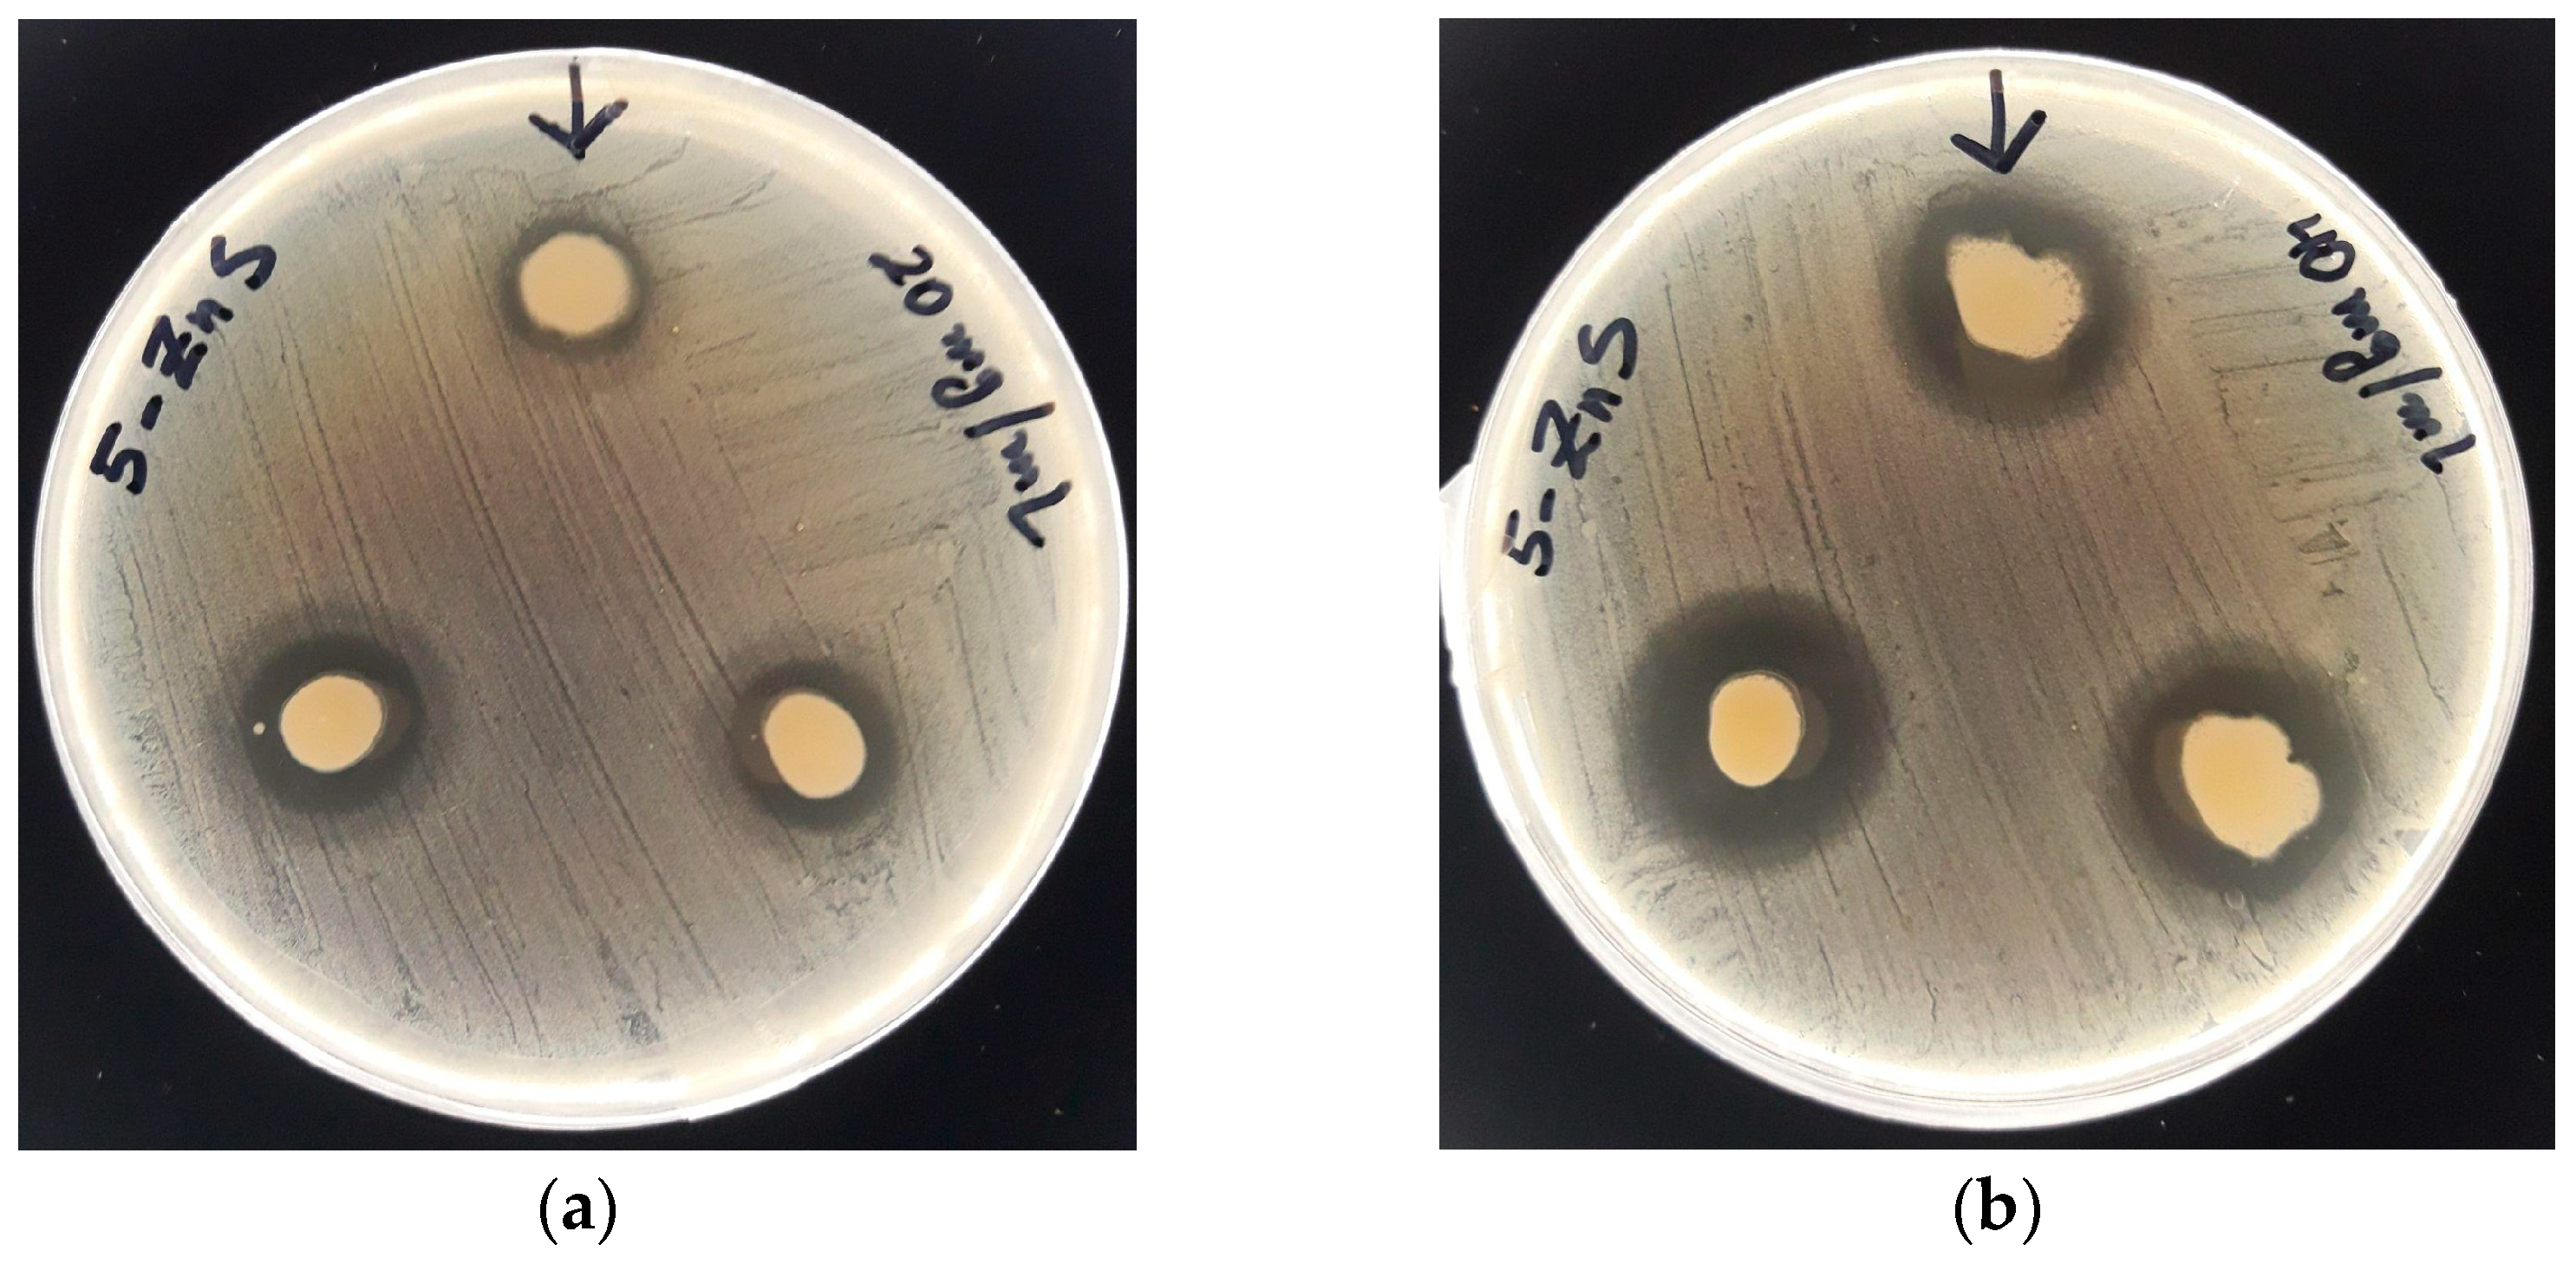
Nanomaterials 13 00935 g008 Nanomaterials 13 00935 g008

Sulfidogenic Bioreactor-Mediated Formation of ZnS Nanoparticles with Antimicrobial and Photocatalytic Activity
Abstract
1. Introduction
2. Materials and Methods
2.1. Synthesis of ZnS Nanoparticles
2.2. Characterization Techniques
2.3. Photocatalytic Degradation Test
2.4. Antibacterial Assays
3. Results and Discussion
3.1. ZnS NPs Characterization
3.2. Photocatalytic Activity
3.3. Antibacterial Activity
4. Conclusions
Author Contributions
Funding
Data Availability Statement
Acknowledgments
Conflicts of Interest
References
- Nobahar, A.; Melka, A.B.; Mar’in-Beltrán, I.; Neves, L.; Costa, M.C.; Carlier, J.D. Zinc Recovery from an Extreme Copper-Free Acid Mine Drainage: Studying the Prior Separation of Ferric Iron by Solvent Extraction Using AliCy and/or Alkalinization. J. Sustain. Metall. 2022, 8, 1509–1531. [Google Scholar] [CrossRef]
- González, D.; Liu, Y.; Gomez, D.V.; Southam, G.; Hedrich, S.; Galleguillos, P.; Colipai, C.; Nancucheo, I. Performance of a Sulfidogenic Bioreactor Inoculated with Indigenous Acidic Communities for Treating an Extremely Acidic Mine Water. Miner. Eng. 2019, 131, 370–375. [Google Scholar] [CrossRef]
- Nancucheo, I.; Segura, A.; Hernández, P.; Hernández-Montelongo, J.; Pesenti, H.; Arranz, A.; Benito, N.; Romero-Sáez, M.; Contreras, B.; Díaz, V.; et al. Covellite Nanoparticles with High Photocatalytic Activity Bioproduced by Using H2S Generated from a Sulfidogenic Bioreactor. J. Environ. Chem. Eng. 2022, 10, 107409. [Google Scholar] [CrossRef]
- Xu, X.; Li, S.; Chen, J.; Cai, S.; Long, Z.; Fang, X. Design Principles and Material Engineering of ZnS for Optoelectronic Devices and Catalysis. Adv. Funct. Mater. 2018, 28. [Google Scholar] [CrossRef]
- Panda, D.; Tseng, T.Y. One-Dimensional ZnO Nanostructures: Fabrication, Optoelectronic Properties, and Device Applications. J Mater Sci 2013, 48, 6849–6877. [Google Scholar] [CrossRef]
- Xu, X.; Ma, S.; Xu, X.; Pei, S.; Han, T.; Liu, W. Transformation Synthesis of Heterostructured SnS2/ZnS Microspheres for Ultrafast Triethylamine Detection. J. Alloys. Compd. 2021, 868, 159286. [Google Scholar] [CrossRef]
- Yang, Z.; Wu, Q.; Zhou, X.; Cao, F.; Yang, X.; Zhang, J.; Li, W. A Seed-Mediated and Double Shell Strategy to Realize Large-Size ZnSe/ZnS/ZnS Quantum Dots for High Color Purity Blue Light-Emitting Diodes. Nanoscale 2021, 13, 4562–4568. [Google Scholar] [CrossRef] [PubMed]
- Jacob, J.M.; Rajan, R.; Tom, T.C.; Kumar, V.S.; Kurup, G.G.; Shanmuganathan, R.; Pugazhendhi, A. Biogenic Design of ZnS Quantum Dots-Insights into Their in-Vitro Cytotoxicity, Photocatalysis and Biosensing Properties. Ceram. Int. 2019, 45, 24193–24201. [Google Scholar] [CrossRef]
- Derikvandi, H.; Nezamzadeh-Ejhieh, A. An Effective Wastewater Treatment Based on Sunlight Photodegradation by SnS2–ZnS/Clinoptilolite Composite. Solid. State. Sci. 2020, 101, 106127. [Google Scholar] [CrossRef]
- Ye, Z.; Kong, L.; Chen, F.; Chen, Z.; Lin, Y.; Liu, C. A Comparative Study of Photocatalytic Activity of ZnS Photocatalyst for Degradation of Various Dyes. Optik 2018, 164, 345–354. [Google Scholar] [CrossRef]
- Aqeel, M.; Ikram, M.; Asghar, A.; Haider, A.; Ul-Hamid, A.; Naz, M.; Imran, M.; Ali, S. Synthesis of Capped Cr-Doped ZnS Nanoparticles with Improved Bactericidal and Catalytic Properties to Treat Polluted Water. Appl. Nanosci. 2020, 10, 2045–2055. [Google Scholar] [CrossRef]
- Mintcheva, N.; Gicheva, G.; Panayotova, M.; Wunderlich, W.; Kuchmizhak, A.A.; Kulinich, S.A. Preparation and Photocatalytic Properties of CdS and ZnS Nanomaterials Derived from Metal Xanthate. Materials 2019, 12(20), 3313. [Google Scholar] [CrossRef]
- Mintcheva, N.; Gicheva, G.; Panayotova, M.; Kulinich, S.A. Room-Temperature Synthesis of ZnS Nanoparticles Using Zinc Xanthates as Molecular Precursors. Materials 2020, 13, 171. [Google Scholar] [CrossRef] [PubMed]
- Onwudiwe, D.C.; Adeyemi, J.O.; Papane, R.T.; Bobinihi, F.F.; Hosten, E. Synthesis, Optical and Structural Characterisation of ZnS Nanoparticles Derived from Zn(Ii) Dithiocarbamate Complexes. Open. Chem. 2021, 19, 1134–1147. [Google Scholar] [CrossRef]
- Othman, A.A.; Osman, M.A.; Ali, M.A.; Mohamed, W.S.; Ibrahim, E.M.M. Sonochemically Synthesized Ni-Doped ZnS Nanoparticles: Structural, Optical, and Photocatalytic Properties. J. Mater. Sci. Mater. Electron. 2020, 31, 1752–1767. [Google Scholar] [CrossRef]
- Sabaghi, V.; Davar, F.; Fereshteh, Z. ZnS Nanoparticles Prepared via Simple Reflux and Hydrothermal Method: Optical and Photocatalytic Properties. Ceram. Int. 2018, 44, 7545–7556. [Google Scholar] [CrossRef]
- You, J.; Liu, C.; Feng, X.; Lu, B.; Xia, L.; Zhuang, X. In Situ Synthesis of ZnS Nanoparticles onto Cellulose/Chitosan Sponge for Adsorption–Photocatalytic Removal of Congo Red. Carbohydr. Polym. 2022, 288, 119332. [Google Scholar] [CrossRef]
- Tairi, L.; Messai, Y.; Bourzami, R.; Chetoui, A.; Sebais, M.; Tahraoui, T.; Bouarroudj, T.; Bezzi, H.; Mekki, D.E. Enhanced Photoluminescence and Photocatalytic Activity of Ca2+ Addition into ZnS Nanoparticles Synthesized by Hydrothermal Method. Physica. B. Condens. Matter. 2022, 631, 413713. [Google Scholar] [CrossRef]
- Xin, M.; Liao, L.-M.; Han, F. Optical Properties of ZnS: Ce Nanocrystals Prepared by Hydrothermal Method. J. Lumin. 2021, 238, 118074. [Google Scholar] [CrossRef]
- Bednář, J.; Svoboda, L.; Manč’ik, P.; Dvorsk`y, R. Synthesis of ZnS Nanoparticles of Required Size by Precipitation in Aerosol Microdroplets. Mater. Sci. Technol. 2019, 35, 775–781. [Google Scholar] [CrossRef]
- Lalithadevi, B.; Rao, K.M.; Ramananda, D. Investigations on Structural and Optical Properties of Starch Capped ZnS Nanoparticles Synthesized by Microwave Irradiation Method. Chem. Phys. Lett. 2018, 700, 74–79. [Google Scholar] [CrossRef]
- Kannan, S.; Subiramaniyam, N.P.; Sathishkumar, M. A Novel Green Synthesis Approach for Improved Photocatalytic Activity and Antibacterial Properties of Zinc Sulfide Nanoparticles Using Plant Extract of Acalypha Indica and Tridax Procumbens. J. Mater. Sci. Mater. Electron. 2020, 31, 9846–9859. [Google Scholar] [CrossRef]
- Alijani, H.Q.; Pourseyedi, S.; Mahani, M.T.; Khatami, M. Green Synthesis of Zinc Sulfide (ZnS) Nanoparticles Using Stevia Rebaudiana Bertoni and Evaluation of Its Cytotoxic Properties. J. Mol. Struct. 2019, 1175, 214–218. [Google Scholar] [CrossRef]
- Hernández, P.; Recio, G.; Canales, C.; Schwarz, A.; Villa-Gomez, D.; Southam, G.; Nancucheo, I. Evaluation of Operating Conditions on Sulfate Reduction from Acidic Wastewater in a Fixed-Bed Bioreactor. Miner. Eng. 2022, 177, 107370. [Google Scholar] [CrossRef]
- Castro-Severyn, J.; Pardo-Esté, C.; Mendez, K.N.; Fortt, J.; Marquez, S.; Molina, F.; Castro-Nallar, E.; Remonsellez, F.; Saavedra, C.P. Living to the High Extreme: Unraveling the Composition, Structure, and Functional Insights of Bacterial Communities Thriving in the Arsenic-Rich Salar de Huasco Altiplanic Ecosystem. Microbiol. Spectr. 2021, 9, e00444-21. [Google Scholar] [CrossRef]
- Ňancucheo, I.; Rowe, O.F.; Hedrich, S.; Johnson, D.B. Solid and Liquid Media for Isolating and Cultivating Acidophilic and Acid-Tolerant Sulfate-Reducing Bacteria. FEMS Microbiol. Lett. 2016, 363(10), fnw083. [Google Scholar] [CrossRef]
- Jang, J.S.; Yu, C.J.; Choi, S.H.; Ji, S.M.; Kim, E.S.; Lee, J.S. Topotactic Synthesis of Mesoporous ZnS and ZnO Nanoplates and Their Photocatalytic Activity. J. Catal. 2008, 254, 144–155. [Google Scholar] [CrossRef]
- Balayeva, N.O.; Mamiyev, Z.Q. Synthesis and Studies of CdS and ZnS-PE/NBR Modified Thermoplastic Elastomeric Copolymer Nanocomposite Films. Mater. Lett. 2016, 162, 121–125. [Google Scholar] [CrossRef]
- Mamiyev, Z.Q.; Balayeva, N.O. Optical and Structural Studies of ZnS Nanoparticles Synthesized via Chemical in Situ Technique. Chem. Phys. Lett. 2016, 646, 69–74. [Google Scholar] [CrossRef]
- Ayodhya, D.; Veerabhadram, G. Fabrication of Schiff Base Coordinated ZnS Nanoparticles for Enhanced Photocatalytic Degradation of Chlorpyrifos Pesticide and Detection of Heavy Metal Ions. J. Materiomics. 2019, 5, 446–454. [Google Scholar] [CrossRef]
- Wageh, S.; Ling, Z.S.; Xu-Rong, X. Growth and Optical Properties of Colloidal ZnS Nanoparticles. J. Cryst. Growth 2003, 255, 332–337. [Google Scholar] [CrossRef]
- Mendil, R.; Ayadi, Z.b.; Djessas, K. Effect of Solvent Medium on the Structural, Morphological and Optical Properties of ZnS Nanoparticles Synthesized by Solvothermal Route. J. Alloys Compd. 2016, 678, 87–92. [Google Scholar] [CrossRef]
- Jacques, I. Pankove, Optical Processes in Semiconductors; Dover: New York, NY, USA, 1971. [Google Scholar]
- Wood, D.L.; Tauc, J.S. Weak Absorption Tails in Amorphous Semiconductors. Phys. Rev. B 1972, 5, 3144. [Google Scholar] [CrossRef]
- la Porta, F.A.; Andres, J.; Li, M.S.; Sambrano, J.R.; Varela, J.A.; Longo, E. Zinc Blende versus Wurtzite ZnS Nanoparticles: Control of the Phase and Optical Properties by Tetrabutylammonium Hydroxide. Phys. Chem. Chem. Phys. 2014, 16, 20127–20137. [Google Scholar] [CrossRef]
- Mosquera, E.; Carvajal, N. Low Temperature Synthesis and Blue Photoluminescence of ZnS Submicronparticles. Mater. Lett. 2014, 129, 8–11. [Google Scholar] [CrossRef]
- Vijayan, S.; Dash, C.S.; Umadevi, G.; Sundararajan, M.; Mariappan, R. Investigation of Structural, Optical and Antibacterial Activity of ZnS Nanoparticles. J. Clust. Sci. 2021, 32, 1601–1608. [Google Scholar] [CrossRef]
- Mathew, S.; Ani Joseph, S.; Radhakrishnan, P.; Nampoori, V.P.N.; Vallabhan, C.P.G. Shifting of Fluorescence Peak in CdS Nanoparticles by Excitation Wavelength Change. J. Fluoresc. 2011, 21, 1479–1484. [Google Scholar] [CrossRef] [PubMed]
- Madhusudan, P.; Wang, Y.; Chandrashekar, B.N.; Wang, W.; Wang, J.; Miao, J.; Shi, R.; Liang, Y.; Mi, G.; Cheng, C. Nature Inspired ZnO/ZnS Nanobranch-like Composites, Decorated with Cu(OH)2 Clusters for Enhanced Visible-Light Photocatalytic Hydrogen Evolution. Appl. Catal. B 2019, 253, 379–390. [Google Scholar] [CrossRef]
- Bär, M.; Ennaoui, A.; Klaer, J.; Kropp, T.; Saez-Araoz, R.; Lehmann, S.; Grimm, A.; Lauermann, I.; Loreck, C.; Sokoll, S.; et al. Intermixing at the Heterointerface between ZnS/Zn(S,O) Bilayer Buffer and CuInS2 Thin Film Solar Cell Absorber. J. Appl. Phys. 2006, 100, 64911. [Google Scholar] [CrossRef]
- Liao, Y.; Xu, H.; Liu, W.; Ni, H.; Zhang, X.; Zhai, A.; Quan, Z.; Qu, Z.; Yan, N. One Step Interface Activation of ZnS Using Cupric Ions for Mercury Recovery from Nonferrous Smelting Flue Gas. Environ. Sci. Technol. 2019, 53, 4511–4518. [Google Scholar] [CrossRef] [PubMed]
- Liu, C.; Qiu, Y.; Wang, F.; Wang, K.; Liang, Q.; Chen, Z. Design of Core–Shell-Structured ZnO/ZnS Hybridized with Graphite-like C3N4 for Highly Efficient Photoelectrochemical Water Splitting. Adv. Mater. Interfaces 2017, 4, 1700681. [Google Scholar] [CrossRef]
- Ajibade, P.A.; Solomane, N.; Sikakane, B.M. Morphological Studies and Photocatalytic Degradation of Methylene Blue by Zinc Sulfide Nanoparticles. Chalcogenide Lett. 2022, 19. [Google Scholar] [CrossRef]
- Ahamad, T.; Naushad, M.; Al-Saeedi, S.I.; Almotairi, S.; Alshehri, S.M. Fabrication of MoS2/ZnS Embedded in N/S Doped Carbon for the Photocatalytic Degradation of Pesticide. Mater. Lett. 2020, 263, 127271. [Google Scholar] [CrossRef]
- Yazdani, E.B.; Mehrizad, A. Sonochemical Preparation and Photocatalytic Application of Ag-ZnS-MWCNTs Composite for the Degradation of Rhodamine B under Visible Light: Experimental Design and Kinetics Modeling. J. Mol. Liq. 2018, 255, 102–112. [Google Scholar] [CrossRef]
- Wang, H.J.; Cao, Y.; Wu, L.l.; Wu, S.S.; Raza, A.; Liu, N.; Wang, J.Y.; Miyazawa, T. ZnS-Based Dual Nano-Semiconductors (ZnS/PbS, ZnS/CdS or ZnS/Ag2S,): A Green Synthesis Route and Photocatalytic Comparison for Removing Organic Dyes. J. Environ. Chem. Eng. 2018, 6, 6771–6779. [Google Scholar] [CrossRef]
- Hu, L.; Chen, F.; Hu, P.; Zou, L.; Hu, X. Hydrothermal Synthesis of SnO2/ZnS Nanocomposite as a Photocatalyst for Degradation of Rhodamine B under Simulated and Natural Sunlight. J. Mol. Catal. A Chem. 2016, 411, 203–213. [Google Scholar] [CrossRef]
- Zhang, X.; Shan, C.; Ma, S.; Zhao, S.; Yang, J. Synthesis of Nano-ZnS by Lyotropic Liquid Crystal Template Method for Enhanced Photodegradation of Methylene Blue. Inorg. Chem. Commun. 2022, 135, 109089. [Google Scholar] [CrossRef]
- Guo, J.; Khan, S.; Cho, S.H.; Kim, J. Preparation and Immobilization of Zinc Sulfide (ZnS) Nanoparticles on Polyvinylidene Fluoride Pellets for Photocatalytic Degradation of Methylene Blue in Wastewater. Appl. Surf. Sci. 2019, 473, 425–432. [Google Scholar] [CrossRef]
- Zhu, B.; Cheng, H.; Ma, J.; Kong, Y.; Komarneni, S. Efficient Degradation of Rhodamine B by Magnetically Separable ZnS– ZnFe2O4 Composite with the Synergistic Effect from Persulfate. Chemosphere 2019, 237, 124547. [Google Scholar] [CrossRef]
- Mani, S.K.; Manickam, S.; Muthusamy, V.; Thangaraj, R. Antimicrobial Activity and Photocatalytic Degradation Properties of Zinc Sulfide Nanoparticles Synthesized by Using Plant Extracts. J. Nanostruct. 2018, 8, 107–118. [Google Scholar] [CrossRef]
- Kumar, R.; Sakthivel, P.; Mani, P. Structural, Optical, Electrochemical, and Antibacterial Features of ZnS Nanoparticles: Incorporation of Sn. Appl. Phys. A Mater. Sci. Process 2019, 125, 543. [Google Scholar] [CrossRef]
- Pourmoslemi, S.; Seif, F.; Mahjub, R. Enhanced Antibacterial Activity of Ag-Doped ZnS Nanoparticles Synthesised by a Microwave-Assisted Polyol Method. Mat. Res. Innov. 2021, 25, 399–403. [Google Scholar] [CrossRef]

| Sample | Synthesis Method | Size (nm) | Dye Concentration | Photocatalyst | K Rate (min−1) | Reference |
|---|---|---|---|---|---|---|
| ZnS | Coprecipitation | 40 | MB-50 mg/L | 0.5 mg/mL | 0.02 | [10] |
| ZnS | Lyotropic Liquid crystal template | 60–200 | MB-20 mg/L | 1 mg/mL | 0.04 | [48] |
| ZnS | Green-synthesis | 11.8 | MB-10 mg/L | 5 mg/mL | 0.002 | [8] |
| ZnS-PVDF | Coprecipitation | 90 | MB 10 mg/L | 5 mg/mL | 0.0163 | [49] |
| ZnS | Sulfidogenic bioreactor | 107 | MB 10 mg/L | 1 mg/mL | 0.004 | This work |
| ZnS-Ag | Sonochemical method | 15 | RhB 10 mg/L | 1 mg/mL | 0.25 | [45] |
| ZnS | Ion exchange method | >10 | RhB 4.8 mg/mL | 1 mg/mL | 0.0008 | [46] |
| SnO2-ZnS | Hydrothermal | 65 | RhB 10 mg/L | 1 mg/mL | 0.046 | [47] |
| ZnS–ZnFe2O4 | Hydrothermal | 100–200 | RhB 20 mg/L | 0.6 mg/mL | 0.0031 | [50] |
| ZnS | Sulfidogenic bioreactor | 107 | RhB 10 mg/L | 1 mg/mL | 0.0059 | This work |
| ZnS Concentration | Inhibition Zone (mm) | |||||||
|---|---|---|---|---|---|---|---|---|
| E. coli | E. cloacae | K. pneumoniae | P. aeruginosa | S. aureus | Bacillus sp. | E. faecalis | S. saprophyticus | |
| 20 mg/mL | 17.5 ± 0.5 | 0.0 ± 0.0 | 0.0 ±0.0 | 0.0 ± 0.0 | 14 ± 1 | 0.0 ± 0.0 | 0.0 ± 0.0 | 0.0 ± 0.0 |
| 40 mg/mL | 21 ± 1 | 0.0 ± 0.0 | 14.0 ± 0.7 | 0.0 ± 0.0 | 21 ± 1 | 10.4 ± 0.6 | 0.0 ± 0.0 | 16 ± 2 |
Disclaimer/Publisher’s Note: The statements, opinions and data contained in all publications are solely those of the individual author(s) and contributor(s) and not of MDPI and/or the editor(s). MDPI and/or the editor(s) disclaim responsibility for any injury to people or property resulting from any ideas, methods, instructions or products referred to in the content. |
© 2023 by the authors. Licensee MDPI, Basel, Switzerland. This article is an open access article distributed under the terms and conditions of the Creative Commons Attribution (CC BY) license (https://creativecommons.org/licenses/by/4.0/).
Share and Cite
Segura, A.; Rodriguez, A.; Hernández, P.; Pesenti, H.; Hernández-Montelongo, J.; Arranz, A.; Benito, N.; Bitencourt, J.; Vergara-González, L.; Nancucheo, I.; et al. Sulfidogenic Bioreactor-Mediated Formation of ZnS Nanoparticles with Antimicrobial and Photocatalytic Activity. Nanomaterials 2023, 13, 935. https://doi.org/10.3390/nano13050935
Segura A, Rodriguez A, Hernández P, Pesenti H, Hernández-Montelongo J, Arranz A, Benito N, Bitencourt J, Vergara-González L, Nancucheo I, et al. Sulfidogenic Bioreactor-Mediated Formation of ZnS Nanoparticles with Antimicrobial and Photocatalytic Activity. Nanomaterials. 2023; 13(5):935. https://doi.org/10.3390/nano13050935
Chicago/Turabian StyleSegura, Aileen, Araceli Rodriguez, Pedro Hernández, Hector Pesenti, Jacobo Hernández-Montelongo, Antonio Arranz, Noelia Benito, José Bitencourt, Luis Vergara-González, Iván Nancucheo, and et al. 2023. "Sulfidogenic Bioreactor-Mediated Formation of ZnS Nanoparticles with Antimicrobial and Photocatalytic Activity" Nanomaterials 13, no. 5: 935. https://doi.org/10.3390/nano13050935
APA StyleSegura, A., Rodriguez, A., Hernández, P., Pesenti, H., Hernández-Montelongo, J., Arranz, A., Benito, N., Bitencourt, J., Vergara-González, L., Nancucheo, I., & Recio-Sánchez, G. (2023). Sulfidogenic Bioreactor-Mediated Formation of ZnS Nanoparticles with Antimicrobial and Photocatalytic Activity. Nanomaterials, 13(5), 935. https://doi.org/10.3390/nano13050935

